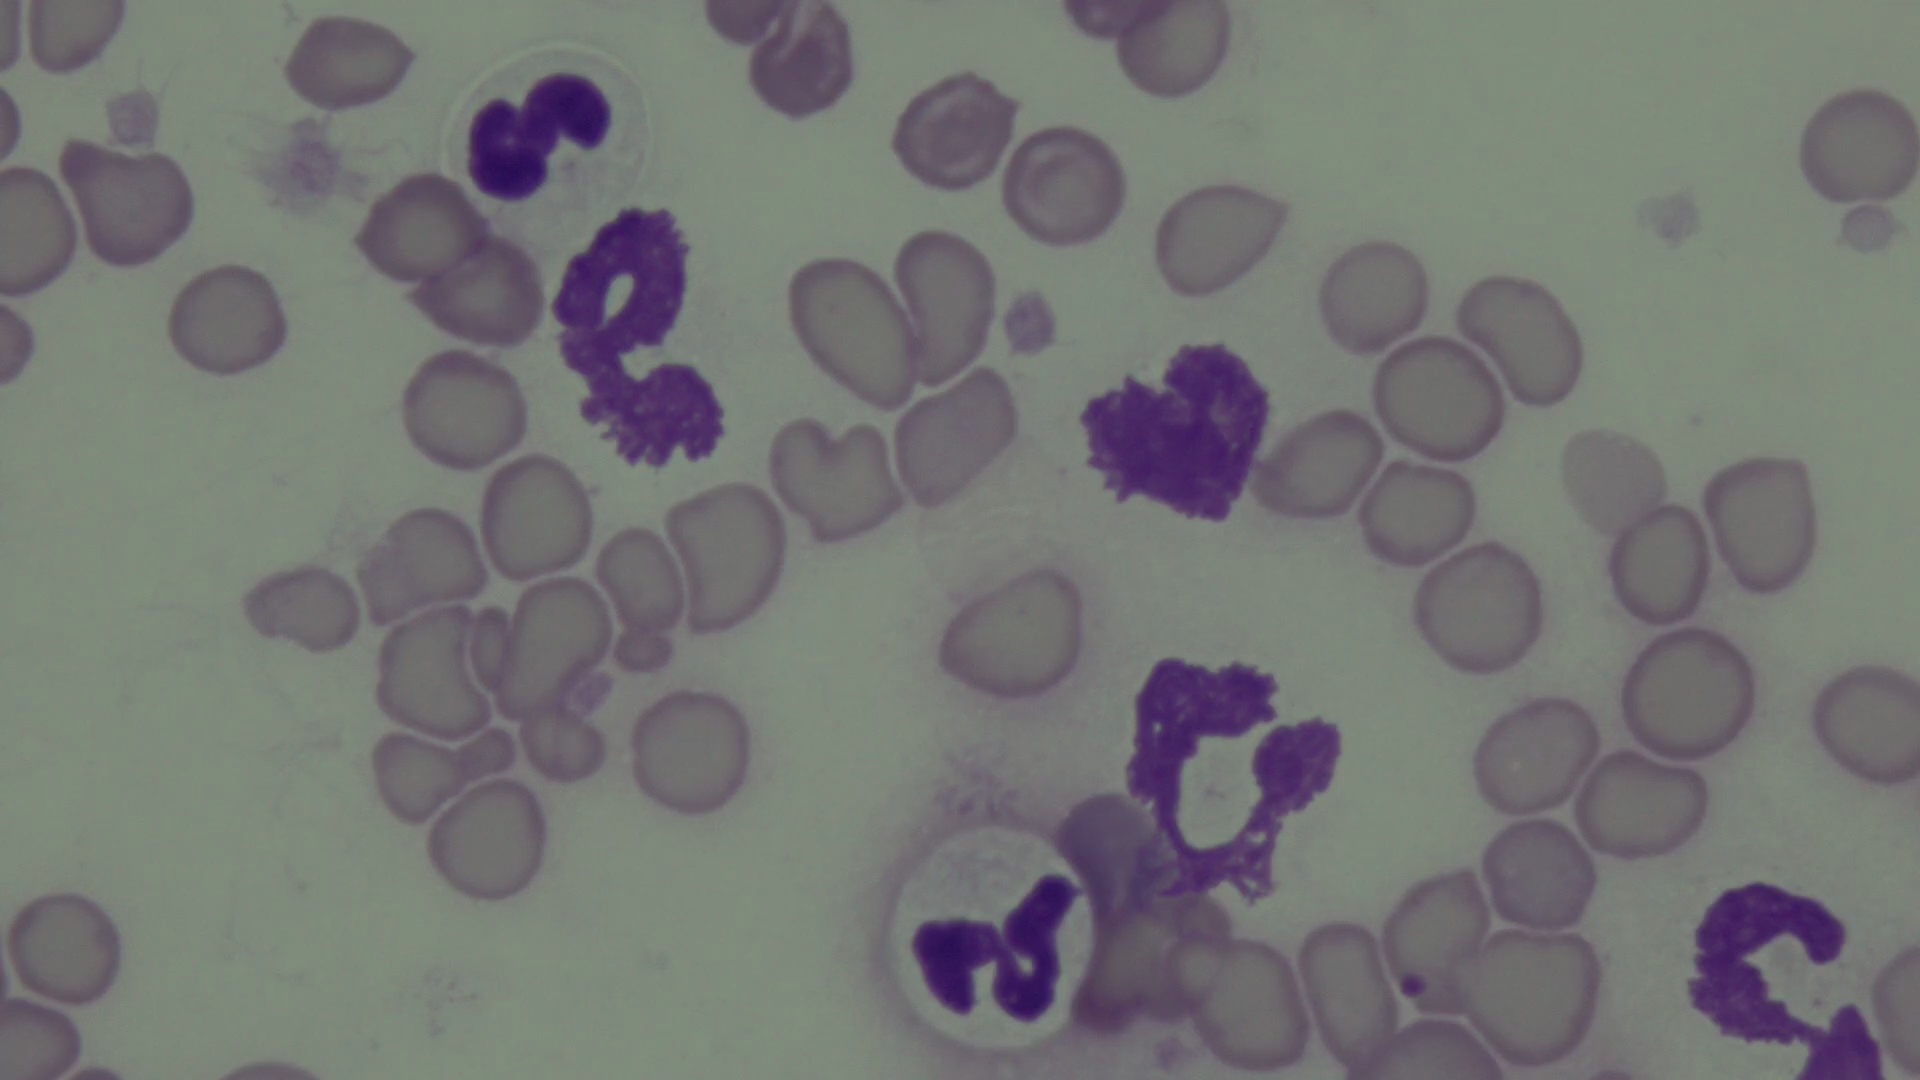

Im Dezember möchten wir unsere wichtigste Grundlage, die Labormedizin, vorstellen. Egal ob beim internistischen Puzzle zur richtigen Diagnose, der Gesundheitsvorsorge oder dem Narkosesicherheitscheck vor Operationen… Die Untersuchung von Blutparametern, Blutausstrichen sind hier nicht wegzudenken. Und da es im Notfall auch mal richtig schnell gehen muss, lieben wir unser Inhouse Labor besonders.
Auch alle zytologischen Untersuchungen, beispielsweise aus Gewebe- oder Tumor Punktionen, werden hier untersucht.
Tanja Hofmeyer und Doreen Meyer sind dabei unsere Joker im Differenzieren von Pathologien unter dem Mikroskop. Aber natürlich gehören die Basisauswertung von Laborparametern, Hormontests und Blutausstrichen bei uns zur Grundausbildung zum Fachtierarzt für Kleintiere dazu.